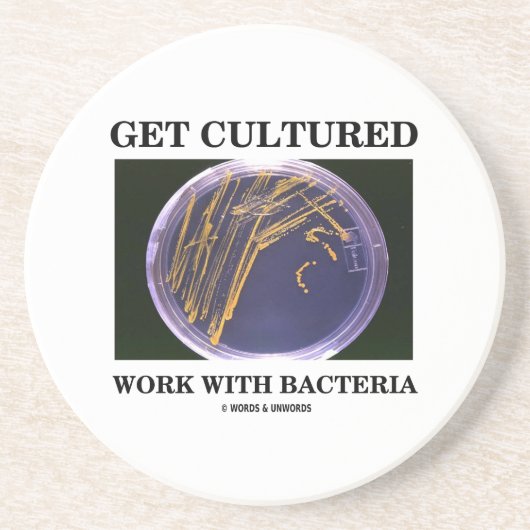
Dessous De Verre En Grès Obtenez le travail cultivé avec des bactéries (le (Devant)

14,05 €
par dessous de verre
Dessous De Verre En Grès Obtenez le travail cultivé avec des bactéries (le
Voir les détails du produitA propos de Dessous de verres
Vendu (e) par
À propos de ce design
Dessous De Verre En Grès Obtenez le travail cultivé avec des bactéries (le
Présentez votre sens de l'humour bactérien tordu avec quelconque d'entre ces cadeaux comportant des bactéries d'un plat d'agar avec le truisme scientifique indiquant que "obtenez le travail cultivé avec des bactéries". Aucun besoin d'être un anthropologue ou un biologiste ou un technicien de laboratoire pour comprendre ce double entendre indiquant impliquant la culture bactérienne ! Cadeaux classiques d'humour de microbiologie pour tous.
Traduction automatique
Avis des clients
Aucun commentaires sur ce produit pour le momentAvez-vous acheté ce produit ?
Tags
Autres infos
Identifiant du produit : 174004683619677627
Fabriqué le 11/11/2014 14:06
Évalué G
Articles vus récemment


